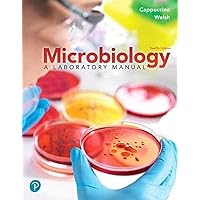

マイストア
変更
お店で受け取る
(送料無料)
配送する
納期目安:
2025.10.15 20:8頃のお届け予定です。
決済方法が、クレジット、代金引換の場合に限ります。その他の決済方法の場合はこちらをご確認ください。
※土・日・祝日の注文の場合や在庫状況によって、商品のお届けにお時間をいただく場合がございます。
Microbiology(微生物学)~海外医学部を6年で卒業プロジェクト~ Amazon.com: Microbiology with Diseases by Body Systemの詳細情報
Amazon.com: Microbiology with Diseases by Body System。Amazon.com: Microbiology with Diseases by Taxonomy。Amazon.com: Microbiology with Diseases by Body System。Summa Cum Laude ~海外医学部を6年で卒業プロジェクト~Microbiology(微生物学)です。Amazon.com: Microbiology with Diseases by Body System。13時間で微生物を全体を網羅。令和2年度1級建築士テキスト問題集。Final Exam 対策に最適です。ロシア語 参考書。細菌、ウィルス、真菌、原虫を含みます。Campe Wörterbuch der deutschen Sprache。A. Bacteria01. Gram + Coccus Species02. Gram + Spore forming Species03. Gram+ Rods.04. Acid Fast Species05. Gram - Coccus Species06. G- Rods.07. Zoonosis08. Mycobacterium Species09. Spirochetes10. AtypicalsB. Virus (44 species)01. DNA viruses02. RNA + strand viruses03. RNA - strand virusesC. Fungi (12 species)01. Systemic Mycosis02. Cutaneious Mycosis.03. Oppotunisitc MycosisD. Parasites (20 species)01. Protozoa02. Helmints対象者:▪米国、ハンガリー、チェコなど英語で医学を学ぶ方▪特に、海外医学部を6年で卒業したい方▪これから医学部留学される方 (本教材で留学前から学習を始められます)▪海外医学部のレベル感を知りたい方(受験前に1科目程度見ておいていいかもしれません)▪留学中で、留年中の方▪USMLE対策。明星大学通信 中高数学 科目修了試験模範解答。日本の医師国家試験対策(※)▪上記のような学生の親御さん。パティシエ Bon Gâteau 全2巻/アシェット•デセール全3巻。(※ どこの国に行っても医学的に重要な点は基本的に同じです。キートレーニング数学演習。著者は日本の国試も半年で合格していますが、日本の国試対策にもとても役に立ったと思います。TAC 一級建築士2024年度 テキスト・問題集セット。)言語: Full English.海外医学部6年で卒業プロジェクトについては、doc.uk.to/m/6/ をご覧ください。最終価格 TAC 電験三種 第3種電気主任技術者 理論講義DVD。(Browserで開いてください。小学校理科 理科プラス 1冊300円。)
ベストセラーランキングです
近くの売り場の商品
カスタマーレビュー
オススメ度 4.5点
現在、3345件のレビューが投稿されています。